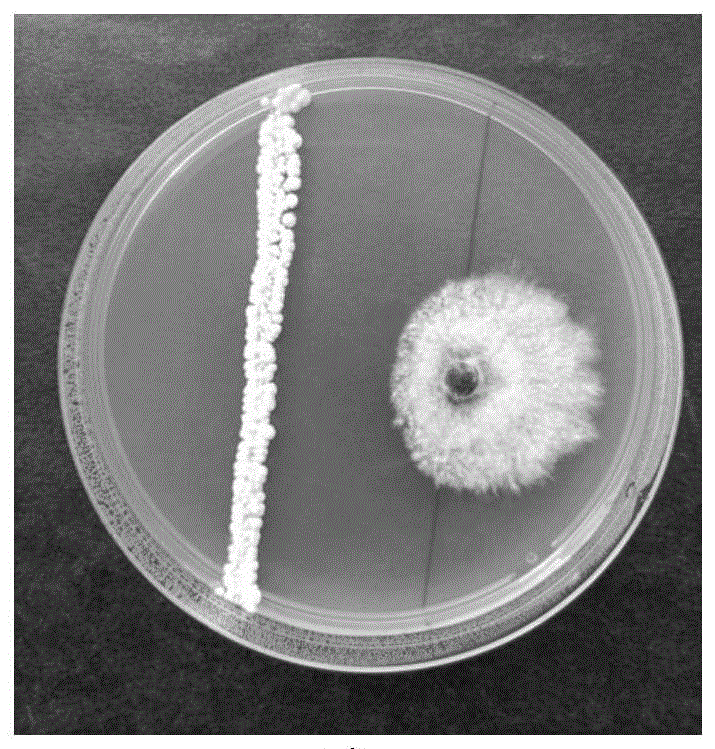
一株吸水鏈霉菌及其應(yīng)用

雙五星
一株吸水鏈霉菌及其應(yīng)用
本發(fā)明涉及一株吸水鏈霉菌及其應(yīng)用����。菌株名稱為吸水鏈霉菌JN3?4(Streptomyces hygroscopicusJN3?4)��,保藏編號(hào)為CGMCC No.27649�����,該菌株及其菌劑可以用于對(duì)聚生小穴殼菌����、紅小豆炭疽病菌�、紅松立枯病菌����、玉米大斑病菌、煙草靶斑病菌��、水稻惡苗病菌��、甜瓜蔓割病菌����、辣椒炭疽病菌���、梨波氏盤果腐病菌��、黃瓜菌核病菌���、藍(lán)莓潰瘍病菌、落葉松枯梢病菌等致病菌的生物防治����,具有生防效果好�、抑菌譜廣���、應(yīng)用范圍廣等優(yōu)點(diǎn)����。
吉林省林業(yè)科學(xué)研究院(吉林省林業(yè)生物防治中心站)
授權(quán)發(fā)明